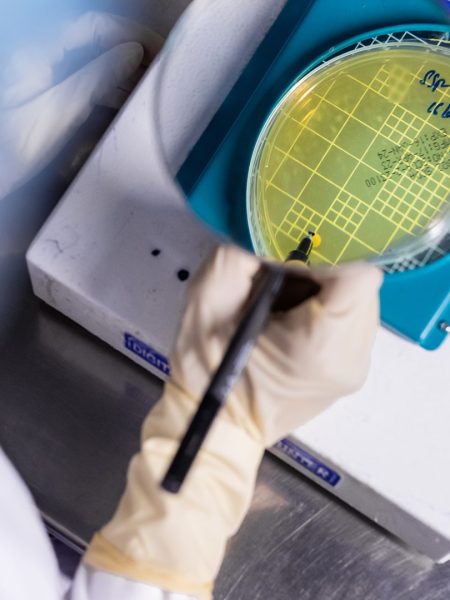

SANZYME
About Us
In the $ 4 billion global Gonadotropin market, we are amongst the first to offer contract manufacturing of human derived Gonadotropins. So far, we are registered in
30 countries and our reach is growing exponentially.
We’ve been manufacturing Gonadotropins for over half a century, now. We are widely recognized as specialists in what we do, and we have made a mark for ourselves with our quality. Our key focus is development and manufacturing of Gonadotropins, Sex Hormones and Speciality probiotics.
We play a key role in assisting several pharmaceutical companies deliver IVF and A.R.T. solutions to their markets.

SANZYME has been awarded a Long term Rating CRISIL A+/Stable and Short Term Rating CRISIL A1+ by CRISIL a S&P Global company.
CAPABILITIES
Focussed on delivering world class products and quality, we at Sanzyme equip ourselves with the best and state of the art centres of excellence. We’ve invested in separate, dedicated manufacturing facilities for Gonadotropin Drug Substance & Drug Product (APIs and Finished Formulations). We have within our set up Bio-analytical, Chemical, Microbiology and Immunoassay laboratories for quality testing and release of these glycoproteins. We have expertise in performing multiple chromatography steps required for purification of these proteins while making our gonadotropin Drug Substance (APIs).
Our Drug Product facility is EU GMP and PIC/s accredited. Our production capacity of ten million gonadotropin vials per annum can be scaled up to double, if need be !!
Our plant located at Genome valley , Hyderabad, is an integrated manufacturing facility that also houses the entire research and development team, onsite to allow for close monitoring of production, required quality checks and process protocols. And, our Quality Control and Bio Labs meet stringent standards as required by global regulatory bodies.
R&D
Approved by DSIR (Department of Science & Research - Ministry of Science and Technology) Enables our primary focus on clinical research, letting us conduct analytical, biological, and microbiological tests and research.

GOING GLOBAL
GETTING WITHIN THE REACH OF EVERY POTENTIAL PATIENT, AND ONTO AISLES OF DRUG STORES ACROSS THE GLOBE.
Your Brand, Our Product
We’ve made inroads into the global market with our contract manufacturing services and expertise, offering world-class fertility drugs and Gonadotropins to pharmaceutical marketing companies across countries backed by CTD. Currently, we are in the process of forging relationships with pharma giants to create a global market for our products under partner companies’ brand name.
Currently, Sanzyme is the largest manufacturer of Gonadotropins requirements of Indian Market Clientele that include such giants as Ferring India, Sun Pharma, Serum Institute of India, JB Pharma to name a few.
Direct To Patients & Fertility Centres
With considerable potential for fertility drugs worldwide, and our legacy as a leading manufacturer and supplier of world class products in India, we have network of our channel partners across global markets, making Sanzyme brands available. In these markets, we work closely with them to ensure that our brands reach to all the end customers locally. We aim to be accessible and reach every prospective patient and the aisle of every drug store across the globe.
PEOPLE & POLICIES
WE ARE CHAMPIONS OF INCLUSIVITY, DIVERSITY AND EQUAL OPPORTUNITY. OUR PEOPLE CARRY OUR VALUES AND ABIDE BY OUR PHILOSOPHY.
PEOPLE
Our strength is the diversity of our people, their ideas and experiences.
We work as a family and we aim to offer the best support, resources and tools they need to grow and perform.
People are committed to the standards of integrity and we value and appreciate them for their contributions.
POLICIES
Integrity, fairness, transparency are the founding principles. Our policies are both inward and outward looking, designed to work positively for our internal and external customers. We aim to maintain a world class working environment, where the best talent can wield the best of resources for some outstanding contribution to the community.
TEAM
BEYOND WORK
CSR & SUSTAINABILITY


We are responsible. We care for our immediate environment and the world at large. We ensure all that we do has no adverse impact on natural resources and the physical environment around us.
Our castle like superstructure—that houses our manufacturing facility—is energy efficient and does not use chemical colours. It is reflective of our commitment to keep things green. We generate part of our energy requirement from solar renewable energy source. We have a zero discharge policy. Effluents are directed to treatment plant. We harvest rain water and do not utilize ground water.
Over 5000 Sq. Mts. OF GREEN BELT; Over 900 TREES AND PLANTS
With sustainability being paramount to us, we implement strategies that reduce their environmental impact and support social and economic development through CSR policies. We employ manufacturing practices that reduce energy and resource consumption, utilize solar energy, minimize waste generation, manage water efficiently through STP/ETP, and minimize packaging waste. We focus on sustainable product development by investing in research and development that reduces environmental impact, improves safety and enhances efficacy.

Since 1969, when we entered into a Joint Venture with Sankyo (now Daiichi-Sankyo) to make gonadotropins to export to Japan, we’ve been at the forefront of biological hormones, and today we have the necessary technological foundation to do path breaking work.
